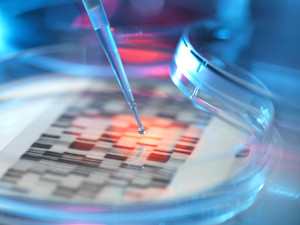

白血病淋巴瘤维奈克拉医保价格,28片孟加拉印度维奈克拉片多少钱一盒一瓶一个月,100mg唯可来印度维奈托克代购哪里买,维奈克拉片效果规格剂量用法,维奈克拉功效与作用新规!
急性髓细胞白血病(AML)是一种起源于骨髓干细胞或祖细胞的恶性疾病,其特点在于骨髓及周围血液中存在异常增生的原始和幼稚髓细胞。患者通常表现出贫血、易出血、感染伴随发热、器官受累及代谢紊乱等症状。大多数AML病例发展迅速且预后严峻,若未及时接受治疗,生命危险极大。艾伯维公司研发的Venetoclax(维奈克拉片)于2016年4月11日获得美国食品药品监督管理局(FDA)的批准上市,成为全球首个Bcl-2抑制剂。维奈克拉(维奈托克)不仅是Bcl-2蛋白抑制剂的同类首创,也是蛋白质相互作用领域首个被批准的小分子药物,标志着医药领域的一个重要进展。至2020年12月2日,维奈克拉片在国内获得批准,可用于联合阿扎胞苷治疗年龄在75岁以上的AML患者。当维奈克拉上市时,按照每日400mg的剂量计算,患者每月需要8盒规格为100mg*14片的维奈克拉,费用约合30680元人民币。白血病淋巴瘤维奈克拉医保价格?
根据官方渠道发布的最新资讯,维奈克拉片(商品名:唯可来)纳入医保目录后,其在2023年的售价调整为:10毫克规格,每盒含14片,售价为282.24元;50毫克规格,每盒含7片,售价为483.84元;100毫克规格,每盒含14片,售价为1645.00元。按照维奈克拉片的常规用量推算,患者完成一个治疗周期(为期28天)所需的花费将超过12000元。老挝孟加拉印度维奈克拉片多少钱一盒一瓶一个月?
印度维奈克拉价格仅为4500至4800元人民币,是患者一个月用量。在成分和效能方面,印度维奈克拉与进口版的维奈克拉保持一致。同时,维奈托克已经在孟加拉、老挝等国家成功推出,价格也公之于众。具体来说,老挝版本每盒含100mg*112粒的价格大约在几千元人民币;而孟加拉版本每盒100mg*60粒的价格也处于相似区间。但是总体而言,印度维奈托克效果更好,100mg唯可来印度维奈克拉哪里买?
1. 可以向身边熟人或周围的人询问,以如果有熟人在印度可以帮助购买,或者直接前往印度一些著名药店亲自选购本地生产的维奈托克。
2. 另一个途径是利用医疗直邮代购,直接联络海外的医疗机构,让印度官方代购平台将正版维奈托克直接寄送到家里,这样的方法在费用上通常比亲自出国购买要划算得多。例如有着6年直邮代购经验的印度康家苑国际海外医疗服务平台【微信kjy163】,口碑好,价格便宜,值得信赖。

维奈克拉片对急性髓白血病有什么用途?印度维奈克拉功效与作用,印度维奈克拉效果
维奈克拉在急性髓系白血病的治疗领域中扮演了关键角色。该药物能够有效促使肿瘤细胞恢复凋亡程序,针对性地消灭那些BCL-2蛋白水平异常升高的肿瘤细胞。BCL-2蛋白作为一种抗凋亡因子,在急性髓系白血病细胞中常常过量存在,阻碍了细胞的正常凋亡过程,导致肿瘤细胞得以延续生命。作为一种可口服的小分子BCL-2抑制剂,维奈克拉能够直接与BCL-2蛋白相互作用,取代其与促凋亡蛋白的结合位点,进而释放促凋亡蛋白以执行其本来的功能,进而促进细胞凋亡的恢复。对于部分因并发症不宜接受强烈诱导化疗的患者,以及年龄在75岁以上的初诊急性髓系白血病患者,维奈克拉和阿扎胞苷的联合治疗方案显示出了一定的治疗潜力。
白血病靶向药——急性髓系白血病
探讨急性髓系白血病,亦称作急性粒细胞白血病或简称急粒,我们现在来了解一下可用于治疗的药物选项。首先是维奈托克,该药物对急性髓系白血病和慢性淋巴细胞白血病显示出良好的疗效。尽管维奈托克尚未在中国市场推出,但在印度和孟加拉已推出其仿制药版本,尽管价格稍高,但仍在可承受范围之内。另一个药物是阿扎胞苷,它通常与维奈托克联合使用,这实际上是一种化疗药物,已在中国上市,尽管价格同样偏高,但印度同样提供了较为经济的仿制药选择。对于国内无法通过医保途径获取药物的患者,印度仿制药或许是一个可行的替代方案。对于急性髓系白血病患者,即急粒患者,在未用药时,你会发现体内存在一种名为BCL-2蛋白的物质。这种蛋白全称为B淋巴细胞瘤2蛋白,其过量存在与急性髓系白血病的发病机理直接相关。维奈托克的作用机理相对明确,它主要针对这种蛋白,如图所示,红色三角形代表维奈托克,它能与BCL-2蛋白上的特定部位结合,使其失去活性。蛋白失活后,病变细胞随之死亡,从而缓解病情。需要注意的是,这种治疗只能缓解症状,而非彻底治愈,尤其是疾病晚期,治愈难度较大。但缓解可以延长患者的无病期和生存期。因此,维奈托克有时也被称为BCL-2抑制剂,这一名称由此而来。
维奈克拉说明书-印度维奈克拉片效果,印度维奈克拉规格剂量用法
【中文名】:维奈克拉片(又称唯可来)
【商品名称】:唯可来
【其他名称】:维奈托克、Venclexta、Venetoclax、Ventcap、维纳妥拉
【研发代码】:ABT-199
【国内维奈克拉剂量与价格】:
- 维奈克拉10mg×14片(每盒1700元)
- 维奈克拉100mg×14片(每盒3000元)
- 维奈克拉50mg×7片(每盒1200元)
【国内是否上市】:已在国内上市
【医保政策】:医院及药店均接受处方购买,并可享受医保报销
【医保报销限定病种】:仅限成人急性髓系白血病患者
【原研厂家】:艾伯维爱尔兰有限公司
【印度厂家】:Caprane
【用法用量、服用方法】:
- 第一个疗程的前三天为剂量递增期。每个疗程的前七天,应与本药品联用阿扎胞苷,阿扎胞苷通过皮下注射给予,剂量为75 mg/m2。
- 本品每日剂量安排如下:
- 第1天:100 mg
- 第2天:200 mg
- 第3天:400 mg
- 第4天起:每日400 mg,每疗程共计28天
- 持续联合阿扎胞苷治疗,直至病情恶化或出现难以忍受的毒性反应。

【不良反应】:
- 常见不良反应(发生率超过30%,包括任何级别)有恶心、腹泻、便秘、中性粒细胞减少、血小板减少、出血、外周水肿、呕吐、疲劳、发热性中性粒细胞减少、皮疹和贫血。
- 约75%的患者报告了严重不良反应。最常见的严重不良反应(占25%)包括发热性中性粒细胞减少、肺炎(不包括真菌性肺炎)、脓毒症(不包括真菌性脓毒症)、呼吸衰竭和多器官功能障碍综合征。
【月用量估算】:按照每日400mg的剂量计算,一个月需使用8盒100mg×14片规格的维奈克拉,总费用约为30680元人民币。
由于正版药物月消费较高,许多患者选择使用仿制药。为此,我们也搜集了相关仿制药信息供大家参考
孟加拉维奈克拉多少钱一盒,印度维奈克拉多少钱一盒一个月,印度维奈克拉多少钱一瓶,各版本维奈克拉价格一览表
1:美国本土研发的维奈托克,其中10毫克/片、共30片的包装,市场定价约为297.33美元,换算成人民币大约是1900元;而50毫克/片、90片的包装,价格则达到4372.81美元,相当于大约28000元人民币。若为100毫克/片、120片的包装,售价为11650.56美元,折合人民币约为74500元。
2:在香港地区发售的版本,通称港版,100毫克/片、120片的包装售价大约为五万元人民币。
3:土耳其市场的维奈托克,100毫克/片、112片的规格,其价格大约在35000元人民币左右。
4:孟加拉和印度版本的维奈克拉,每盒价格介于4500至4800元人民币之间。
5:印度代购的维奈托克为每盒100mg规格、120粒装,当前的市场价格大约在4500至4800元人民币。
比较分析显示:印度版本的维奈克拉在患者中的应用表现出色。因为印度在药物研发上无需承担高昂成本,被誉为“世界药房”的印度能够制造出疗效相同但成本更低的维奈克拉,进而使得更多的患者得以受惠。

100mg唯可来印度维奈克拉代购哪里买
1. 医疗机构和药品零售点:在印度,众多医疗场所及药房均有售维奈托克,但需凭医嘱方可购买。其中包括位于阿姆达巴德、孟买、加尔各答等城市的知名医疗单位内的药房。
2. 专业的医疗服务平台:推荐长期帮助病友从印度直邮发货的平台,例如:印度康家苑国际海外医疗(微信kjy163),常驻印度新德里,与各大药房医院保持良好合作关系,为国内患者提供低价国际快运服务,从印度药房到患者手中,不经第三方,价格便宜,质量可靠。